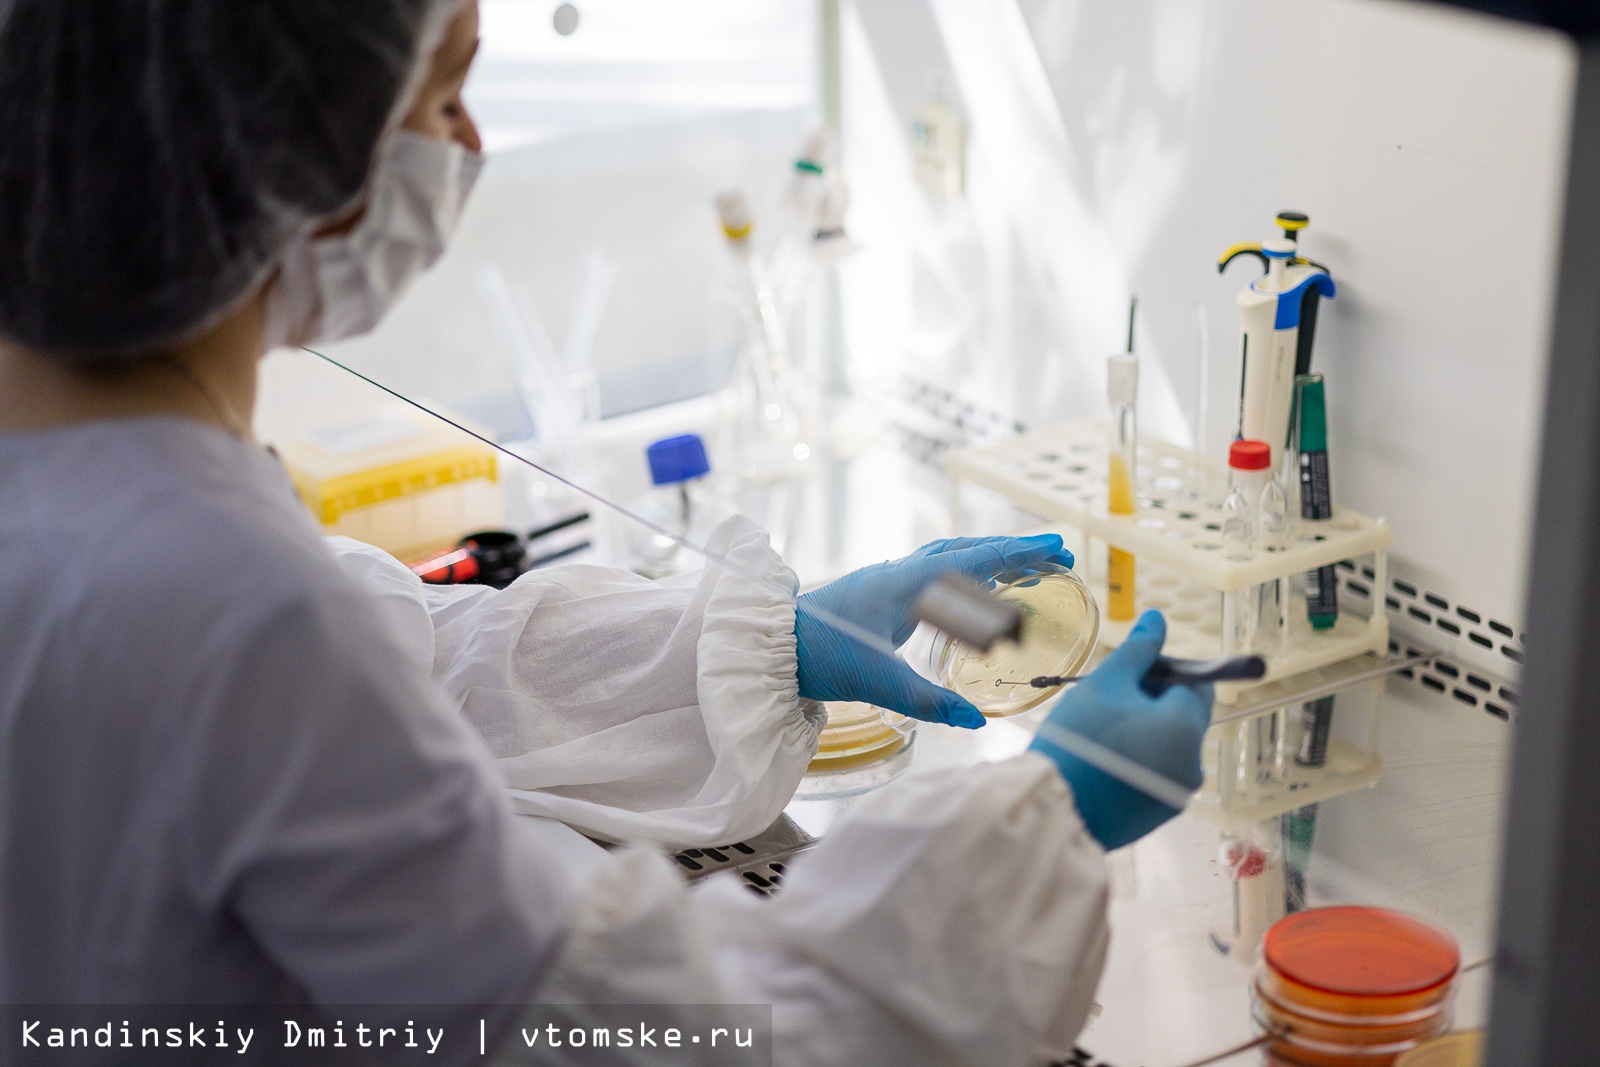

Новая лаборатория для создания технологий в пищевой отрасли открылась на базе ТПУ

Новая микробиологическая лаборатория открылась в Томском политехническом университете, ее оснастила группа компаний «ЭФКО». Новая лаборатория позволит расширить спектр микробиологических работ, выполняемых учеными ТПУ, а также разнообразить практические занятия у студентов.
Напомним, Томский политех и группа компаний «ЭФКО» заключили соглашение о сотрудничестве осенью 2020 года. В прошлом году была достигнута договоренность об открытии микробиологической лаборатории, где будут проходить практические занятия для студентов-химиков, а ученые смогут разрабатывать технологии для пищевого производства.
Лабораторию обустроили в «химическом» корпусе ТПУ. Ремонт помещения и покупка оборудования оцениваются примерно в три миллиона рублей.
В частности, лаборатория включает в себя СО2-инкубатор для выращивания микроорганизмов без доступа кислорода; специальные колонки для хроматографии — метода анализа, применяемого для контроля биотехнологического процесса. Этот прибор, приобретенный с помощью «ЭФКО», позволит политехникам работать, например, с белковыми препаратами. Как отмечают в университете, ученые ТПУ уже частично работают над проектом, связанным с получением сладкого белка.
Кроме того, у ученых есть проекты по работе с растительным сырьем, связанные с определением его качества, безопасности, наличия споровых частиц, микроорганизмов. Эта лаборатория даст возможность контролировать качество исходного сырья, полупродукта и конечного продукта.
«Для нас это большой шаг вперед, в том числе с точки зрения инфраструктурного оснащения, так как сейчас мы сможем проводить исследования по микробиологии в условиях отсутствия кислорода. Это позволит существенно расширить линейку наших исследований», — отметил на открытии лаборатории и.о. ректора Томского политеха Дмитрий Седнев.
По его словам, сейчас ученые согласовывают конкретный план исследований. Большая часть работ будет связана с продовольственной безопасностью.

Директор по персоналу инновационного центра «Бирюч» ГК «ЭФКО» Анна Ворожбянова отметила, что пищевая отрасль сегодня активно развивается в России; есть нерешенные вопросы, над которыми нужно работать.
«Мы думаем, что значимость пищевой отрасли будет расти, и студентов, включая учащихся ТПУ, будет привлекать эта сфера для работы в ней. Компании «ЭФКО» всегда были нужны разные специалисты, мы рады всегда биотехнологам, химикам, инженерам, механикам», — сказала Анна Ворожбянова.
Микробиологическая лаборатория будет доступна и студентам. Здесь планируется проводить практические и лабораторные занятия, сказал и.о. ректора ТПУ. Также в лаборатории будут выполнить выпускные квалификационные работы; студентов будут привлекать к выполнению исследовательских проектов.
«И в этой лаборатории, и в целом на исследовательской инфраструктуре политехнического университета мы увеличиваем вовлеченность студентов. Безусловно, при выходе из вуза ребята должны будут уметь применять свои знания на практике, попросту говоря — уметь работать руками», — отметил Дмитрий Седнев.
Добавим, новая лаборатория открылась в день старта работы в ТПУ Международной практической конференции студентов и молодых ученых «Химия и химическая технология в XXI веке». Это одна из крупнейших российских конференций по химии и химической технологии. В течение четырех дней свои доклады представят более 500 участников из 23 стран.


Партнерский материал


